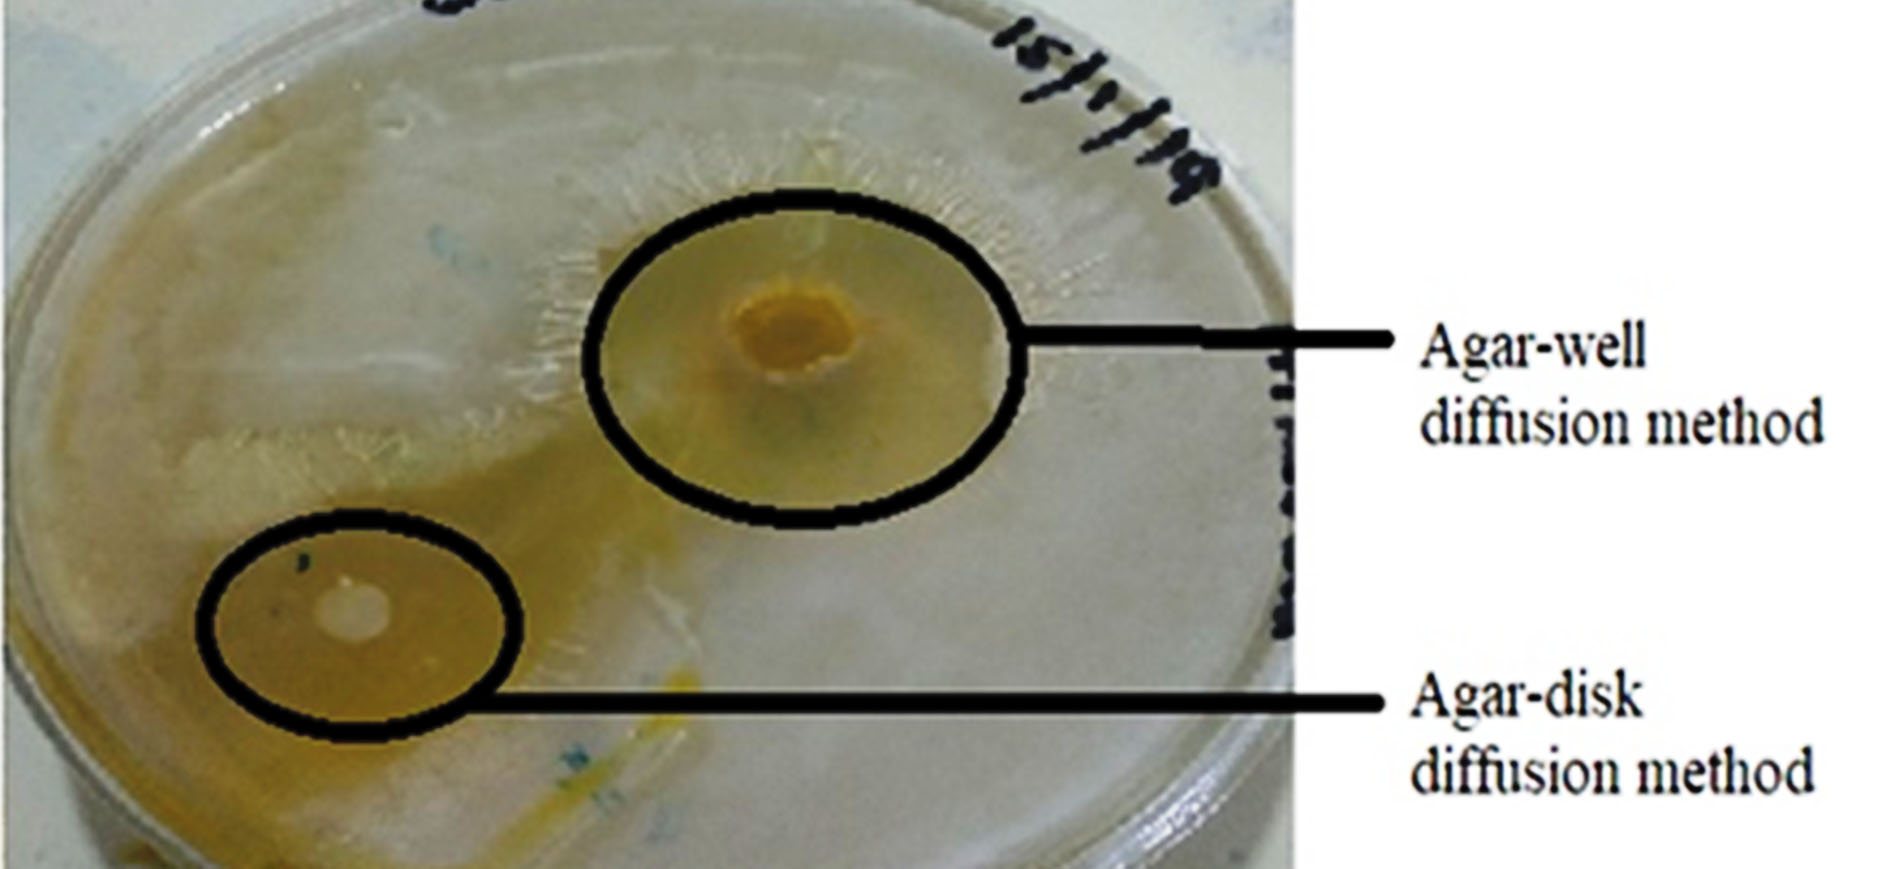
bi-11-23-g006
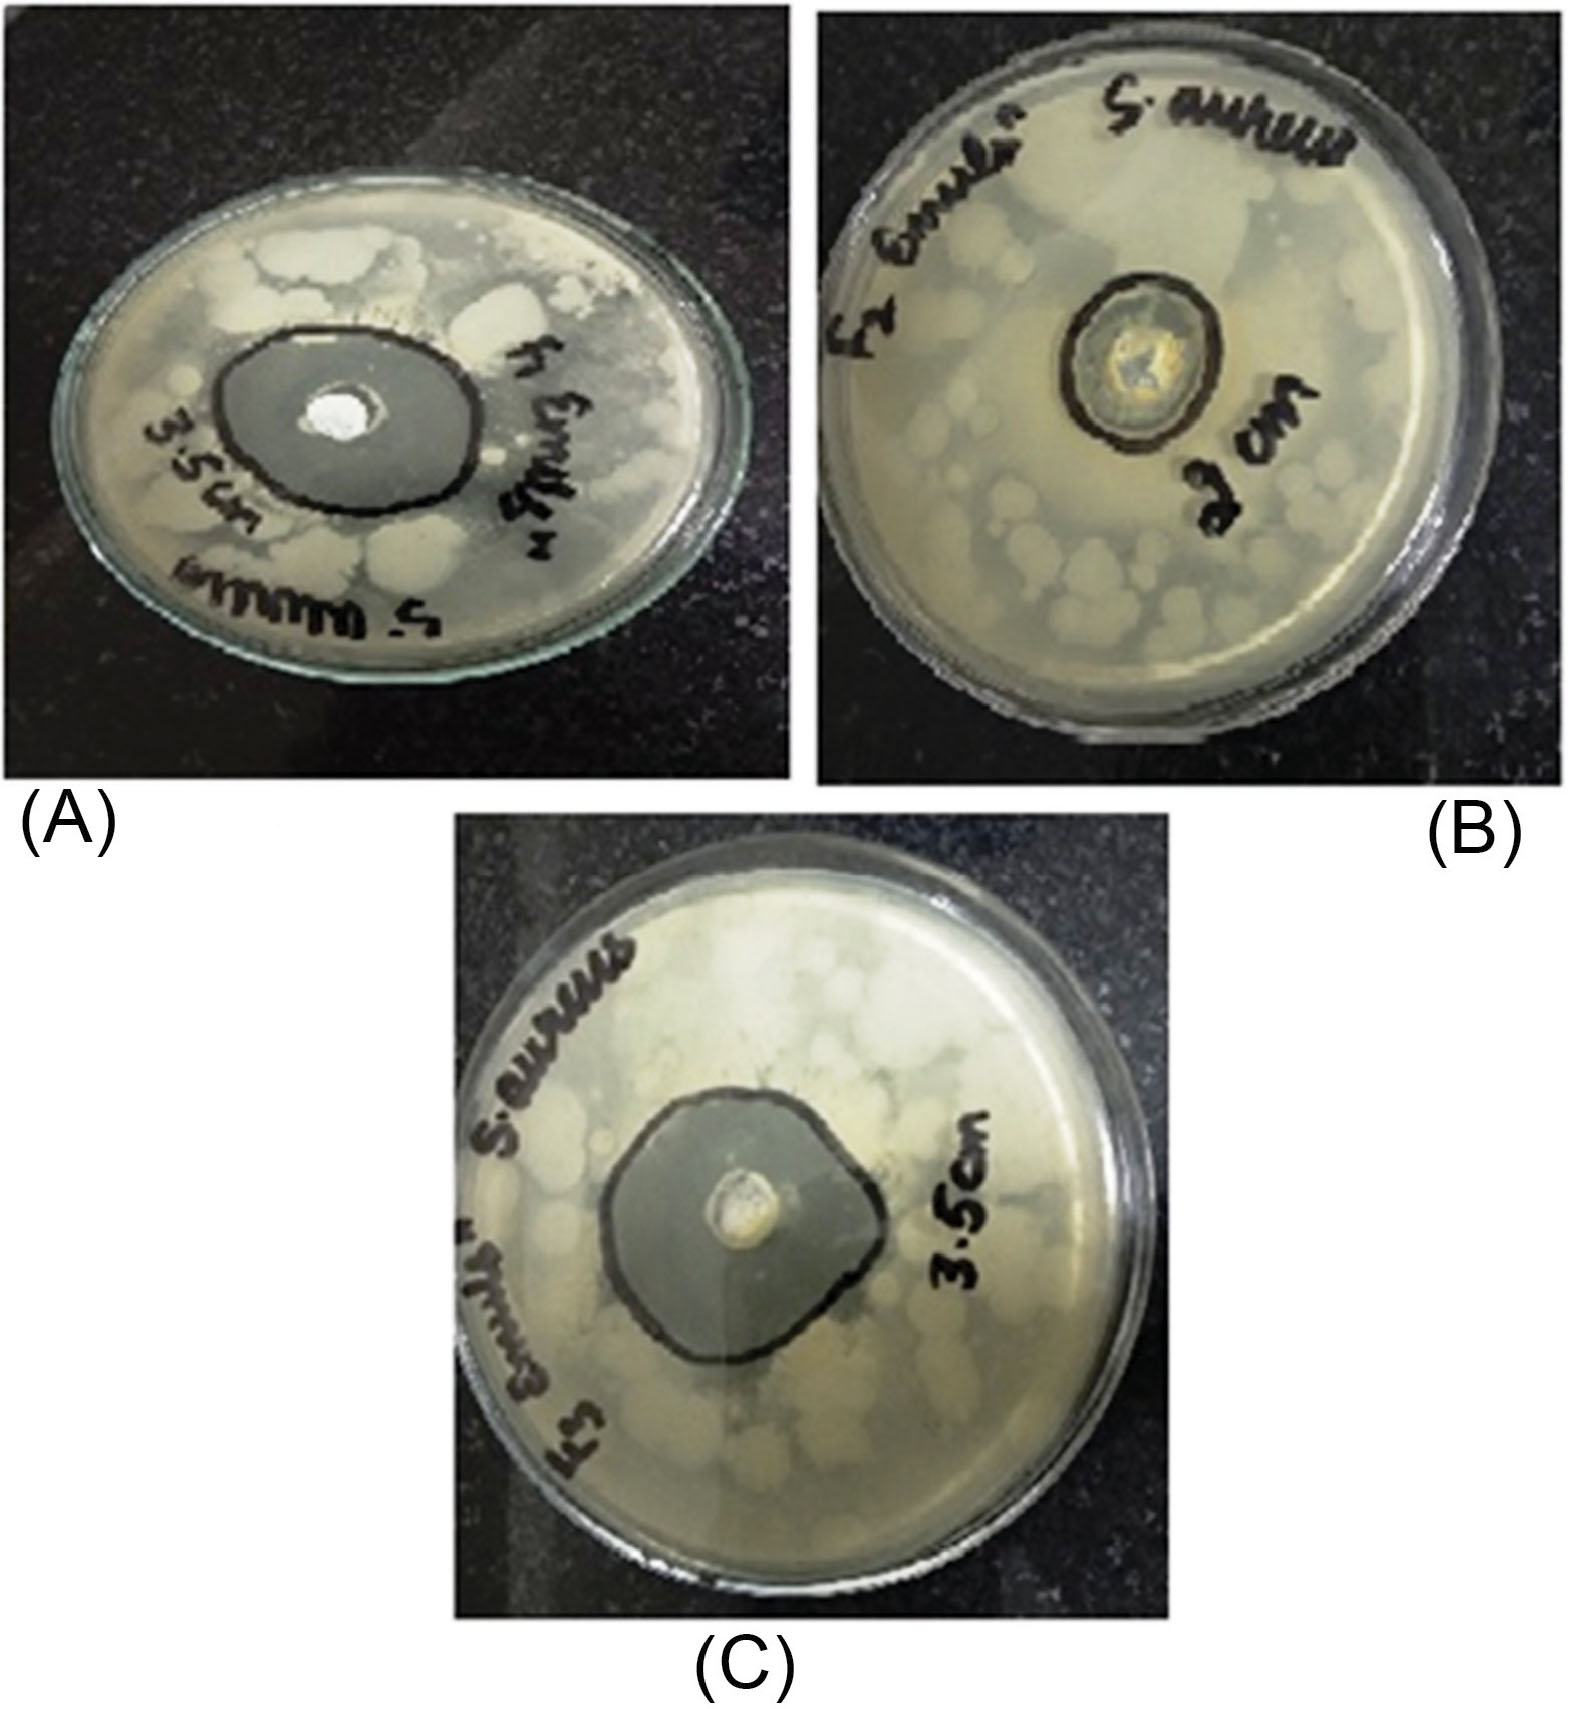
bi-11-23-g007
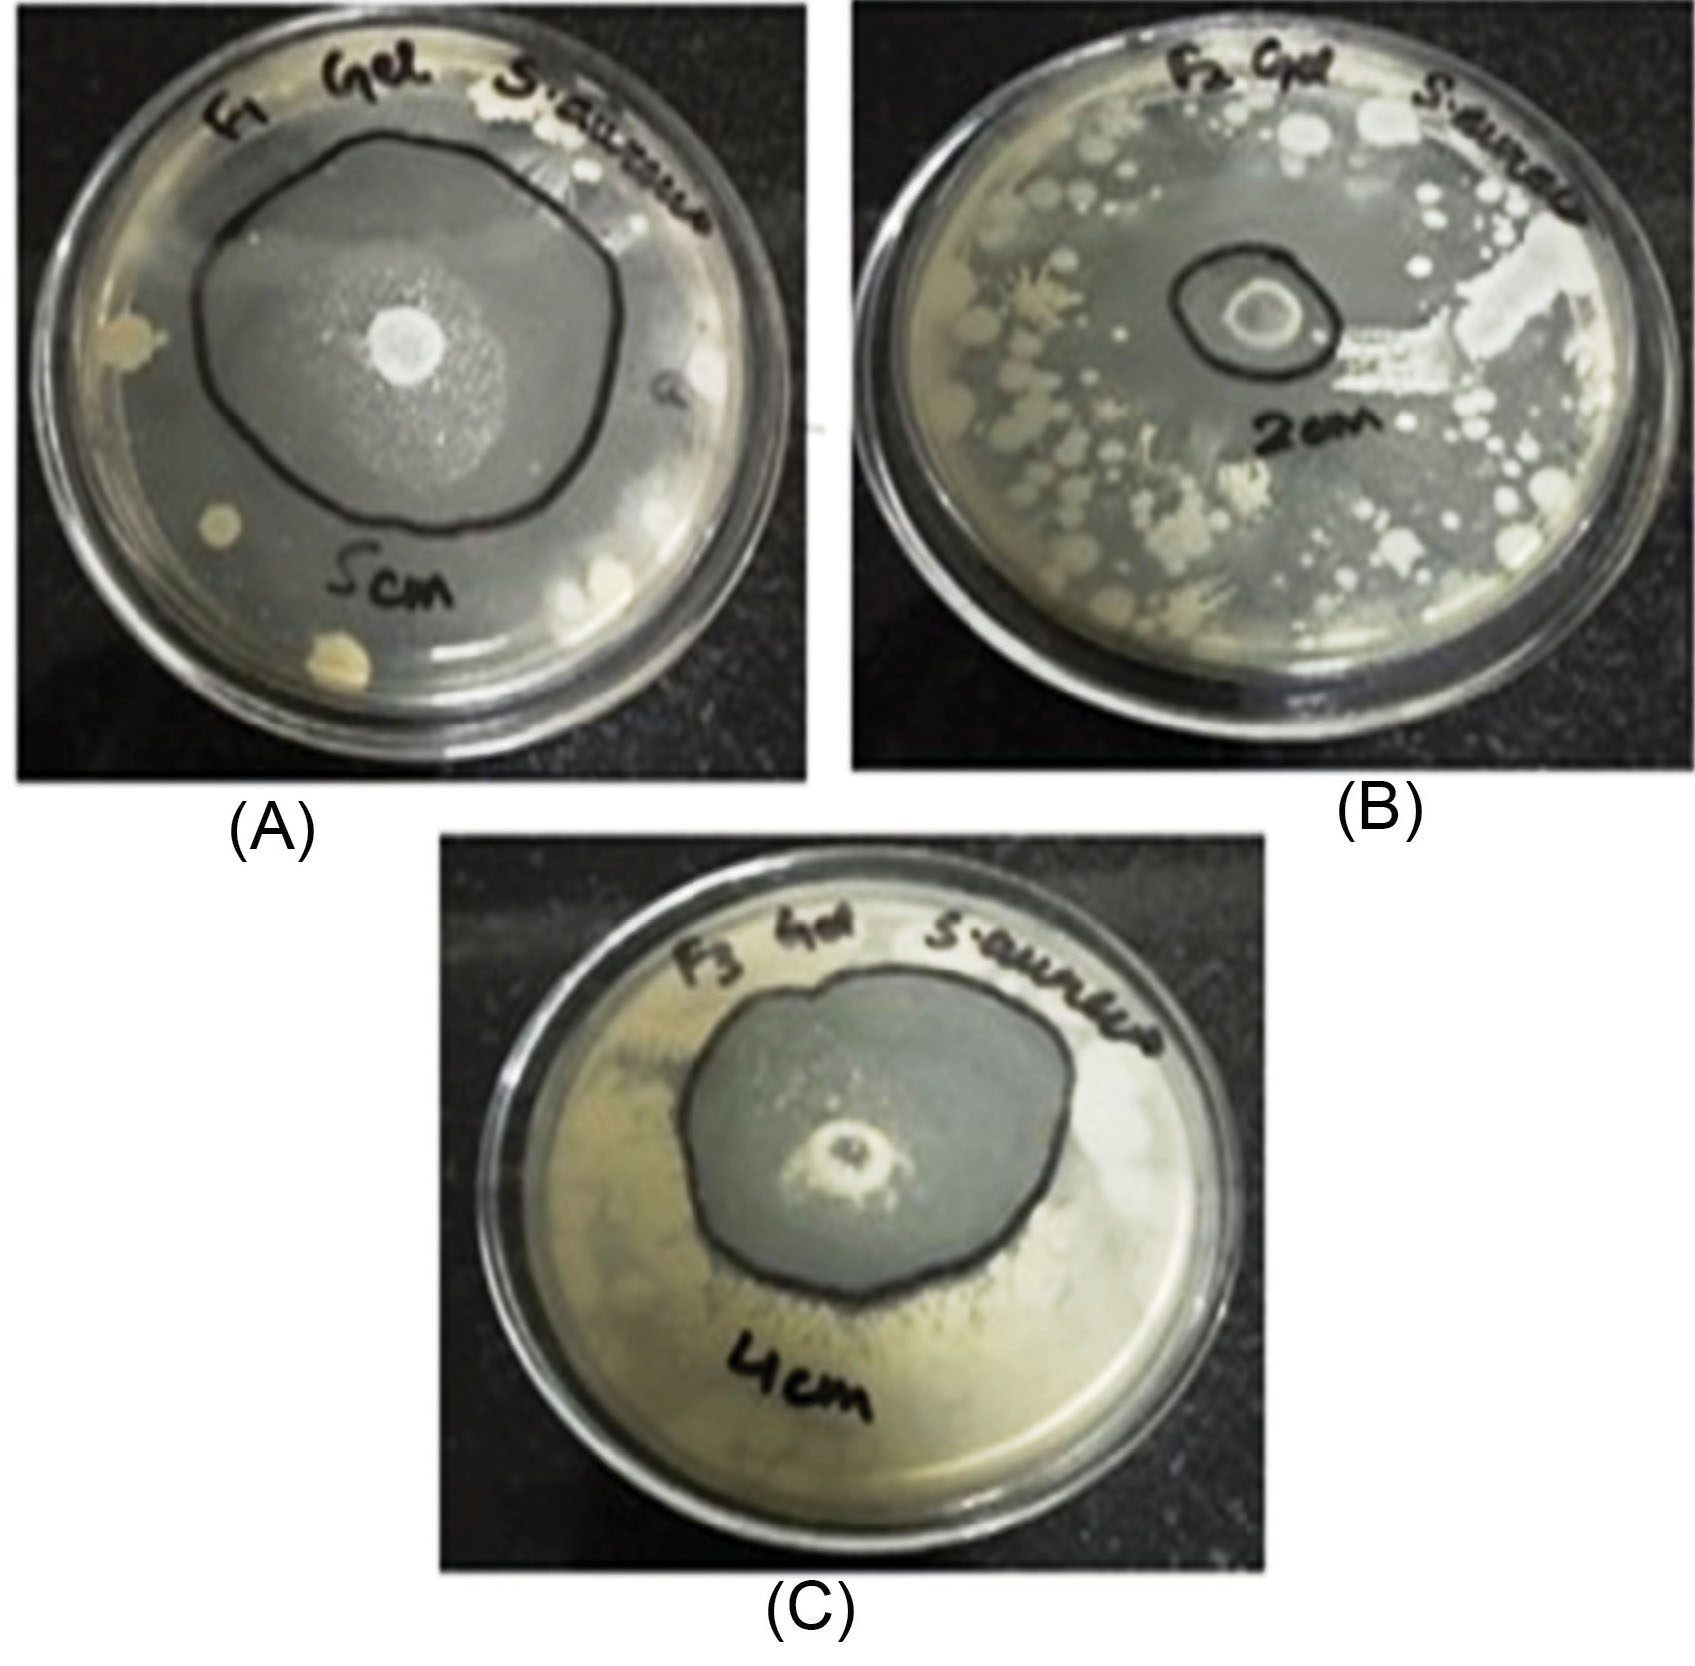
bi-11-23-g008

Bioimpacts. 11(1):23-31.
doi: 10.34172/bi.2021.04
Original Research
Improved antibacterial activity of topical gel-based on nanosponge carrier of cinnamon oil
Malkiet Kaur 1  , Manju Nagpal 1, *
, Manju Nagpal 1, *  , Manjinder Singh 1
, Manjinder Singh 1  , Thakur Gurjeet Singh 2, Geeta Aggarwal 2
, Thakur Gurjeet Singh 2, Geeta Aggarwal 2  , Gitika Arora Dhingra 3
, Gitika Arora Dhingra 3 
Author information:
1Chitkara College of Pharmacy, Chitkara University, Punjab, India
2Delhi Pharmaceutical Sciences and Research University, New Delhi-110017, India
3NCRD’s Sterling Institute of Pharmacy, Nerul, Navi Mumbai, India
Abstract
Introduction:
Cinnamon essential oil (CEO) is a volatile oil, obtained from Cinnamomum zeylanicum has become one of the most important natural oil due to its antimicrobial activity. CEO suffers from various limitations such as instability and skin irritation. This problem has been overcome by formulating CEO-loaded nanosponges incorporated in carbopol gel with increased antimicrobial property and reduced skin irritation.
Methods:
The nanosponges were fabricated by solvent emulsion diffusion method and evaluated for Fourier transform infrared spectroscopy (FTIR) studies, particle size, field emission scanning electron microscopy studies (FE-SEM), in vitro dissolution studies, in vitro antibacterial studies, using agar diffusion method, in vivo antibacterial activity and skin irritation studies and stability studies.
Results:
Nanosponge NS1 batch was found to be in the nanosize range. FTIR studies confirmed the absence of drug-polymer interaction. NS1 confirmed a porous structure with a uniform spherical shape using FE-SEM studies. In vitro dissolution studies of optimized NS1 revealed 80% drug release in 5 h whereas, incorporating the formulation into carbopol gel showed 100% release in 5h from G1 formulation. In vitro antibacterial study of the nanosponge (NS1 and NS3) showed remarkable antibacterial activity as seen from the zone of inhibition and gel formulation G1 also showed the highest zone of inhibition with 50±1.2 mm. NS1 and G1 were stable for 2 months under accelerated conditions and 3 months under room temperature conditions. Furthermore, the in vivo and skin irritation studies were performed with selected formulation against Staphylococcus aureus , where the results confirmed the significant antimicrobial activity with no skin irritation.
Conclusion:
Nanosponge carriers can be more therapeutically effective for essential oils which can further be incorporated into topical gels for convenient application.
Keywords: Nanosponge, Antimicrobial, Essential oil, Skin irritation, Stability, Topical
Copyright and License Information
© 2021 The Author(s)
This work is published by BioImpacts as an open access article distributed under the terms of the Creative Commons Attribution License (
http://creativecommons.org/licenses/by-nc/4.0/
). Non-commercial uses of the work are permitted, provided the original work is properly cited.
Introduction
Antimicrobials are the natural or synthetic agents that hinder the growth of microorganisms or kills microorganisms.
1
The excess use of antibiotics leads to antimicrobial resistance.
2
As synthetic drugs have many disadvantages such as drug resistance and toxicity so, natural products or essentials oils can be used to overcome the side effects. Essential oils (EOs) and Plant extracts have gained much attention due to their antimicrobial activity as well as flavoring agent.
3
“Essential oil” referred to as a product obtained from distillation with water/steam, via mechanical process, vegetable raw material, or by using dry distillation. Conventionally, essential oils have bactericidal, fungicidal, virucidal, insecticidal, antiparasitic, and further therapeutic properties such as sedative, anti-inflammatory, locally anesthetic remedies, analgesic, and spasmolytic.
4
The efficacy of natural products can be determined by its chemical properties and concentration of the effective component present in it. Components having antimicrobial properties include thiosulfinates, glucosinolates, flavonoids, organic acids, saponins, and phenolics.
5,6
The effectiveness of herbal compounds has regained the interest of academicians and researchers for the fabrication of plant-based medicines as the plant products are without any side effects, no drug resistance, easily degradable, and ecofriendly.
7,8
Topically, aromatherapy EOs causes skin irritation if applied directly to the skin. Essential oils may lead to serious side effects when they are applied to broken skin due to their systemic absorption.
9
Being highly volatile, decomposition of EOs due to direct exposure of heat, light, humidity, and oxygen tends to occur. Further, these factors lead to isomerization, dehydrogenation, oxidation, and cyclization reactions which are triggered either enzymatically or chemically. These are strongly influenced by the processing conditions and during the storage of the plant material.
10,11
Cinnamon essential oil (CEO), a volatile oil which is extracted from leaves of Cinnamomum zeylanicumhas been of great importance because of its antimicrobial activity. CEO suffers from various limitations such as instability and skin irritation. Nanotechnology has received a lot of attention with enthusiasm because of its future potential. Various drug delivery systems incorporating cinnamon oil were developed using nanotechnology principles. Cinnamon leaf oil nanocream was formulated for topical application,
12
chitosan-cinnamon oil nanoparticles were prepared for enhanced shelf life and controlled release,
13
O/W emulsion of cinnamon oil nanoparticles was formulated for active food packaging applications
14
and liposomes of cinnamon oil were formulated for methicillin-resistant Staphylococcus aureus (MRSA) biofilm.
15
Nanosponges are spongy, virus size NPs with an average diameter (250 nm-1 μm in diameter). It can be incorporated into oral, topical, parenteral or nasal drug delivery systems. Due to their smaller size and spongy structure drugs can easily bind with them by enhancing the solubility and bioavailability of the drug. Nanosponge reduces the irritation of drugs without reducing their efficacy. Nanosponges can incorporate lipophilic and hydrophilic substances
6
. Researchers studied nanosponge formulations based on essential oils such as lemongrass oilwas incorporated into NS for anti-fungal activity,
16
Babchi oil in CD-NS to improve solubility, photo-stability, and safety of essential oil.
17
To overcome the problems of cinnamon oil, the research aims to formulate CEO-loaded nanosponges incorporated in carbopol gel with increased antimicrobial activity and decreased skin irritation.
Materials and Methods
Materials
Cinnamon oil was obtained from Kanta enterprise Pvt. Ltd, Noida; Polyvinyl alcohol (PVA), Carbopol 940, and ethylcellulose (EC) was purchased from Loba Chemie pvt. Ltd, Mumbai, India.
Methods
Formulation of nanosponge carriers:Nanosponges loaded cinnamon oil (CO) were fabricated using the emulsion solvent diffusion technique. The dispersed phase was prepared by dissolving a specified amount of CO in 10 mL dichloromethane (DCM) having a specific quantity of ethyl cellulose (EC). The dispersed phase was added gradually into an aqueous solution of polyvinyl alcohol with different concentrations (as specified in Table 1) with continuous stirring for 30 minutes to get 3 batches of nanosponges (NS1, NS2, and NS3 respectively).
16
The composition of various nanosponge batches is given below in Table 1.
Table 1.
Composition of various nanosponge batches
|
Formulation/Ratio(EC:PVA)
|
Cinnamon oil (μL)
|
Ethylcellulose (mg)
|
Polyvinyl alcohol (mg)
|
| NS1 (1:1) |
200 |
100 |
100 |
| NS2 (1:2) |
200 |
100 |
200 |
| NS3 (1:3) |
200 |
100 |
300 |
Formulation of topical gel incorporating nanosponge carriers
Carbopol 940 (1% w/v) solution was prepared and kept to swell during all night. Nanosponges were dispersed to carbopol gel with continuous stirring of 10-15 minutes to allow integration of carbopol gel into CEO nanosponges and batches were denoted as G1, G2, and G3. The prepared gel formulations were kept aside for 15 minutes without disturbance to emit entrapped air out and were stored in tightly closed containers at room temperature for further evaluation.
Evaluation of nanosponge carriers
Fourier transform infrared spectroscopy (FTIR) studies
FTIR studies are carried out for the assessment of drug excipient interaction, cross-linking, polymerization, and drug loading in the formulation. The samples were scanned in the range of 4000- 400 cm-1.
18
Particle size analysis
Particle size was evaluated using Malvern Zetasizer. The polydispersity index (PDI) was also calculated. PDI can range from 0 to 1, where 0 stands for monodisperse system and 1 for a polydisperse system.
16
Field emission scanning electron microscopy studies (FESEM)
The FESEM images were acquired via a Carl Zeiss ultra 55 FESEM.
Evaluation of topical gel
Physical appearance
Color and odor was evaluated visually.
Determination of pH
It was evaluated using a digital pH meter. The pH of the gel was measured by dropping the glass electrode into the formulation.
19
Determination of viscosity
The viscosity of the prepared gels was determined using Brookfield viscometer by using spindle no. 64 at 10 rpm and temperature of 25oC.
20
Determination of spreadability
It was evaluated via using a glass slide and wooden block apparatus. The gel formulation (1 g) was kept on a preset glass slide and another movable glass slide was placed over the first glass slide and 50g weight was added to the slide for 5 minutes. The time used for the separation of slides was noted.
20
It can be measured by using the given formula:
S = M×L/T
Where, S = spreadability in g.cm/s
M = mass in grams
T = time in seconds.
Determination of homogeneity
The homogeneity of formulated gels was evaluated visually. The formulations were evaluated for appearance and existence of aggregates.
19
In vitro dissolution studies
The in vitrodissolution studies of nanosponges and gels were carried out on a PERMION diffusion cell apparatus. Nanosponge carriers containing drug equivalent to 100 μL were introduced into dialysis membrane pouches and kept in a beaker filled with phosphate buffer (6.8 pH) at 37 ± 0.5°C. Aliquots were withdrawn at periodic intervals for 5 hours and each time replaced by the same quantity of dissolution medium. Samples were analyzed spectrophotometrically at a particular wavelength.
16
In vitro antimicrobial studies
Preparation of agar plates
The agar plates were prepared by dissolving the agar into the water and were autoclaved for 15 minutes at 121oC. Then, the agar medium was allowed to cool at 40-45oC. 25 mL of molted agar was poured into the petri dishes. The agar plates were allowed to solidify under laminar airflow.
Preparation of inoculum
E. coli (Imtech strain- 1687) and S. aureus (Imtech strain- 1430) were used to estimate the antibacterial efficacy of the topical formulations containing cinnamon oil. The subcultured microorganisms were kept earlier so that the microorganisms must be in their log phase of growth and to ensure the validity of the results.
Inoculation of agar plates
The solidified agar plates were taken and the prepared inoculum was applied to it by streaking method. The plates were kept to dry for 5 min at room temperature.
Preparation of agar well diffusion assay
Agar well diffusion assay is done by above-dried plates. Wells were prepared by using a sterile cork borer by making holes on the inoculated agar plates. Each well was 5 mm in diameter. A weighed amount of the formulation (NS1, NS2, NS3, G1, G2, and G3) was placed into each well. The plates were incubated at 37oC for 72 hours and observed for inhibition zones. The area of the inhibition zones was measured by using a ruler to the nearest millimeter.
20,21
Stability studies
The stability of selected nanosponge carriers and topical gel batch were evaluated for 3 months, under accelerated conditions of temperature and humidity (i.e.40±2°C/75±5%RH) and at room temperature conditions. The formulations were tested for physical appearance and the drug content at intervals of 15, 30, 45, 60, and 90 days.
22
In vivo studies
The organism and preparation of inoculum
Standard strain of S. aureus(1687; Imtech, Mohali) was used for inoculation and determination of antibacterial action of Cinnamon oil. The bacterial colony (CFU/mL) was prepared by the method given below-
The working culture was taken out from the refrigerator 30 minutes before testing to acclimatize with the working environment and place it under laminar airflow in the culture handling room.
The loop was heated until it gets red hot; a loop full of culture was taken and inoculated in 25 mL of sterile Soyabean Casein Digest broth medium.
The medium was incubated at 35.2 ± 2.5oC for 24-48 hours for bacterial cultures.
Minimum Inhibitory Concentration (MIC)
MIC was determined by using broth macro-dilution assay. Cinnamon oil stock solution (30 000 ppm) was prepared in phosphate buffer saline (PBS). The nutrient broth was prepared by two-fold dilutions (up to 1875 ppm), and an inoculum of S. aureus (1*104 CFU/mL) was added to each tube. The tube contents were mixed and incubated (at 35oC) for 18-20 hours and then the turbidity of the tubes was checked by naked eyes. The last dilution at which the growth of the organism was inhibited was reported as MIC of the extract.
23
Animals
Inbred adult Wistar rats of weight (250 ± 20 g) obtained from Chitkara College of Pharmacy, Chitkara University, Punjab India; kept on standard feed and water ad libitumwere used in the current study. The animals were preserved in the departmental animal house and bare to 12 hr cycle of light and dark conditions.
Experimental design
Ten adult Wistar rats were indiscriminately selected and divided into two groups. All the animals were subjected to the experimental procedure for circular excision wound and skin irritation study.
Circular excision wound model
The rats were anesthetized IP with a chloral hydrate (400 mg/kg). The animal's back was cleaned and hairs were shaved. Further, the skin was sterilized by povidone-iodine followed by 70% ethanol solution. A 15-mm circular excision wound was created on the dorsal inter-scapular region of every animal. The skin was carefully dissected out and the wound was left open. Further, rats were inoculated locally with 1*104 CFU of S. aureusat the wound site. The optimized formulation was applied topically twice a day throughout the experiment. Control group animals were not treated with any other formulation.
24
Tissue preparation and culture
After 14 days of applying the formulation; the tissues were collected from animals. Tissues were weighed and homogenized in broth media. The mixture of broth and tissue was used for two 1:10 serial dilutions in Mueller–Hinton broth and transferred to sterile test tubes at 4oC. The samples (each 100 μL), including serial dilutions, were then transferred to tryptone soy agar plates and incubated (at 35oC) for 24 hours. Colony counts were considered accurate for numbers from 30 to 300 and were compared with the serial dilutions and duplicate plates for reproducibility.
25
Colony counts were then translated to colony-forming units per gram using the following formula:
cfu/g = Colony counts * 50* Dilution factor/Specimen weight (g)
Skin irritation test
The irritation effect of gel formulation F1 was evaluated by Draize patch test. The back of the animal was shaved before 24 hours of applying formulation and then, Fl formulation was applied uniformly on the wound site. The skin was evaluated for any visible changes after 24, 48, and 72 hours after the application of gel formulation. The mean erythemal scores were evaluated using grade scores from 0 to 4.
As per the degree of erythema, the grades were recorded as follows:
0 for no erythema;
1 for a slight (light pink discoloration of the skin);
2 for moderate (dark pink);
3 for more severe (light red);
4 for severe (dark red).
Hematoxylin & eosin staining
After the 14th day of the treatment with the optimized formulation and untreated animals, the rat skin was removed and fixed and entrenched in paraffin wax; further sliced (coronal sections; 4 μm thick) and stained with hematoxylin and eosin dye and observed under light microscopy.
25,26
Statistical analysis
Data obtained from the study was statistically analyzed using one-way ANOVA followed by Tukey’s multiple range tests as post hoc analysis. Moreover, analysis of time-course data of the study was also done using two-way ANOVA. The threshold value, P<0.05 was considered to be significant.
Results and Discussion
Evaluation of nanosponge carriers
Fourier transform infrared spectroscopy studies
All characteristic peaks of cinnamon oil were observed in the IR spectra of nanosponge formulations (Fig. 1). No significant shifts are observed in the positions of wavenumbers when compared to pure drug. The data represents the no interaction of cinnamon oil with polymers during nanosponge preparation.

Fig. 1.
Overlay diagram of FTIR of pure Cinnamon oil, PVA, EC, and Nanosponges formulation (NS1)
.
Overlay diagram of FTIR of pure Cinnamon oil, PVA, EC, and Nanosponges formulation (NS1)
Particle size analysis
The nanosponge formulations (NS1 and NS3) were evaluated for particle size, PDI. The prepared nanosponge formulations were found to be in nanosize (200-600 nm). The particle size of nanosponge formulations was found to be 224.1 of NS1 and 536.6 of NS3 (shown in Figs. 2 and 3). The polydispersity values of nanosponge formulation were in the range of 0.056-0.330 indicating the narrow distribution of particle size within the formulation. The low PDI signifies the uniformity of particle size within the formulations.

Fig. 2.
The particle size distribution of NS1.
.
The particle size distribution of NS1.

Fig. 3.
The particle size distribution of NS3.
.
The particle size distribution of NS3.
The effect of the drug: polymer ratio on the particle size of nanosponge was evaluated. As the polymer concentration increases, the size of particles increases. It may be revealed that at low polymer concentration and higher drug ratio, the polymer available to encapsulate the drug is not sufficient. The thickness of polymer is thereby reduced which leads to small nanosponges.
Field emission scanning electron microscopy (FESEM) studies
The prepared nanosponges carriers were observed as spherical shaped particles porous network. Fine orifices on the surface of nanosponges may be created via diffusion of DCM from the surface of the nanocarrier during their preparation. The FESEM image of NS1 nanosponge is shown in Fig. 4.

Fig. 4.
FESEM images of Nanosponge batch.
.
FESEM images of Nanosponge batch.
Formulation of topical gel incorporating nanosponge carriers
Three batches of topical gels were formulated (G1, G2, and G3) incorporating nanosponge carriers and further evaluated.
Physical appearance
The prepared topical gels were examined for various physicochemical parameters and results are depicted in Table 2.
Table 2.
Physicochemical characteristics of topical gels
|
Formulation code
|
Appearance
|
Color
|
pH
|
Viscosity (cps)
|
Spreadability (g cm/s)
|
Homogeneity
|
| G1 |
White |
Colorless |
5.6 |
35992 |
44.82 |
Good |
| G2 |
White |
Colorless |
5.3 |
37072 |
20 |
Good |
| G3 |
White |
Colorless |
5.2 |
34973 |
28.01 |
Good |
In vitro drug release studies
In vitro release profile of various nanosponges and topical gels is shown in Fig. 5. The drug release from nanosponges was observed in the order of NS1>NS2>NS3. Maximum 80% drug release was achieved in NS1 formulation. The nanosponges were further incorporated into carbopol gel and three gel formulations (G1, G2, and G3) were evaluated for drug release. The drug release from topical gels was significantly higher than that of corresponding nanosponge formulations. The order of drug release was G1>G3>G2.

Fig. 5.
In vitro drug release from various nanosponge and Gels formulations.
.
In vitro drug release from various nanosponge and Gels formulations.
The drug release at higher ratios of PVA was decreased and it could be due to increased thickness of nanosponge matrices which leads to increased diffusional distance and therefore reduced drug release rates.
In vitro antimicrobial studies
The in vitroantibacterial study was performed by measuring and comparing the diameter of the zone of inhibition (mm) for the various formulations of nanosponges (NS1, NS2, and NS3) and gels (G1, G2, and G3). A weighted amount of cinnamon oil was used as the control in the study. The antibacterial activity of Cinnamon oil against S. aureus was significant and is seen in Fig. 6. The antibacterial activity of cinnamon oil nanosponges (NS1, NS2, and NS3) and gel formulations (G1, G2, and G3) was measured against S. aureusand results are shown in Fig. 7, Fig. 8 and Table 3. The nanosponge NS1 and NS3 showed remarkable antibacterial activity as seen from the zone of inhibitions while NS2 showed a small zone of inhibition. The same order of activity against S. aureus was observed in corresponding gel formulations G1, G2, and G3. The G1 batch showed the highest zone of inhibition (5 cm) and based upon these observations (1:1 ratio of EC and PVA) was considered to be optimum. The higher amount of PVA may create a thick layer surrounding the nanosponges which leads to slow diffusion of active component to exhibit the antimicrobial effect. This suggests the antimicrobial potential of cinnamon oil against specific bacteria and it is also supported by the literature. The results of 1:2 ratios of EC and PVA are not clear.
Fig. 6.
Zone of inhibition of Cinnamon oils.
.
Zone of inhibition of Cinnamon oils.
Fig. 7.
Zone of inhibition of Nanosponge formulations (NS1, NS2, NS3) against S. aureus
.
Zone of inhibition of Nanosponge formulations (NS1, NS2, NS3) against S. aureus
Fig. 8.
Zone of inhibition of topical gel formulations (G1, G2, and G3) against S. aureus
.
Zone of inhibition of topical gel formulations (G1, G2, and G3) against S. aureus
Table 3.
Antimicrobial activity of nanosponge carriers and topical gels
|
Microorganism
|
Zone of inhibition (mm)
|
|
NS1
|
NS2
|
NS3
|
G1
|
G2
|
G3
|
|
S. aureus
|
35± 1.6 |
20± 1.3 |
35±2.4 |
50± 1.2 |
20±1.6 |
40± 1.9 |
Stability studies
The stability studies of nanosponge and topical gel formulation were carried out in the stability chamber (Remi SC-10 [plus]) under accelerated conditions of temperature (40 ± 2oC) and relative humidity (75% ± 5) and room temperature conditions for three months. At accelerated conditions, topical gel (G1) remained stable as observed by physical appearance (no viscosity change and color change) for 3 months and but the nanosponge formulation (NS1) was stable for 45 days after that it breaks as observed visually.
The topical gel (G1) and nanosponge formulation (NS1) kept at room temperature conditions remained stable for 3 months.
In vivo studies
Effect of optimized formulation on bacterial load
14th day after bacterial exposure the microbial load was estimated in both treated and untreated control groups on the wound site with a cotton swab test. The bacterial count in two groups i.e. disease control and the optimized formulation was 5.2 × 105 and 56, respectively. The optimized formulation has shown a significant difference (P≤ 0.05) in the bacterial count when compared with the untreated group. The result of the present study has revealed that topical gel formulation (G1) at the infected wound site produces prominent antimicrobial activity against S. aureus when compared with the untreated control group.
Histopathology
There is epidermal remodeling in the disease control group. Fibroblast proliferation is prominent along with the infiltration of neutrophils. Foreign body cells were localized in the dermis. In the treatment group, the normal texture of the dermis, the epidermis was observed with very few neutrophils. The cross-sectional skin specimens of full-thickness from each group were collected and evaluated for the histopathological alterations, at the end of the experiment. Samples were fixed in 10% buffered formalin, processed and blocked with paraffin and cut into 5 m sections, and further stained with hematoxylin and eosin (H&E). The histopathological view of disease control and treatment group is given below in Fig. 9.

Fig. 9.
(a) Histopathological view of Disease Control; (b) Histopathological view of treatment Group.
.
(a) Histopathological view of Disease Control; (b) Histopathological view of treatment Group.
Effect of optimized formulation on skin irritation
The skin irritation score was recorded on the 14th day. Optimized gel formulation of cinnamon oil has shown no local and systemic effects. Morphological and histopathological evaluation of skin samples applied with optimized formulation (G1) showed no significant gross pathological changes, skin irritation, edema, redness, or toxic effects, and the microscopic evaluation was found to be unremarkable.
Conclusion
Nanotechnology also plays a vital role in the effective delivery of essential oils. As essential oils possess various therapeutic benefits but patient compliance can be a problem due to its odor and viscosity and stability. Nanosponges of cinnamon oil prepared with ethyl cellulose and polyvinyl alcohol using the emulsion solvent diffusion method were found to be a potential carrier for the oil as observed from In vitro antibacterial studies as well as drug release studies. Topical gels incorporating nanosponges were further observed as an effective, stable topical dosage form with improved and sustained release characteristics, which was further proved by In vivo antibacterial including histopathology studies and skin irritation studies. A significant In vivo antibacterial activity was observed in comparison to pure cinnamon oil. Therefore, essential oils can be better applied as nanocarriers incorporated in topical gels.
Acknowledgments
The authors are thankful to Dr. Madhu Chitkara, Vice Chancellor, Chitkara University; Dr. Ashok Chitara, Chancellor, Chitkara University; Dr. Sandeep Arora, Director, Chitkara College of Pharmacy for providing necessary facilities and support.
Funding sources
No funding by any agency.
Ethical statement
The protocol of the experiment was approved by the Institutional Animal Ethical Committee (IAEC) and care of the animals was done as per the guidelines of the Committee for the Purpose of Control and Supervision of Experiments on Animals (CPCSEA), Ministry of Environment and Forests, Government of India. Chitkara College of Pharmacy Animal Facility Registration Number: 1181/PO/ReBI/S/08/CPCSEA.
Conflict of interests
The authors declared no conflicts of interest.
Authors’ contribution
Dr. Manju Nagpal for study design and execution of research work, Dr. Geeta Aggarwal and Dr. Gitika Arora Dhingra as an advisor, Dr. Gurjeet Singh for helping in in vivo studies, Dr. Manjinder Singh for draft preparation and graphical presentation, Malkiet kaur for conducting all the lab work and writing the draft.
Research Highlights
What is the current knowledge?
simple
-
√ Cinnamon oil exhibits significant antibacterial properties but it cannot be used therapeutically as such due to irritation.
What is new here?
simple
-
√ The current study revealed the formulation of nanosponges of cinnamon oil for its better antibacterial efficacy which is revealed in the results of the study.
References
- Raeisi M, Tajik H, Yarahmadi A, Sanginabadi S. Antimicrobial effect of cinnamon essential oil against Escherichia coli and Staphylococcus aureus. Health Scope 2015; 4(4):1-5. doi: 10.17795/jhealthscope-21808 [Crossref] [ Google Scholar]
- Beyth N, Houri-Haddad Y, Domb A, Khan W, Hazan R. Alternative antimicrobial approach: nano-antimicrobial materials. Evid Based Complement Alternat Med 2015; 2015:246012. doi: 10.1155/2015/246012 [Crossref] [ Google Scholar]
- Bilia AR, Guccione C, Isacchi B, Righeschi C, Firenzuoli F, Bergonzi MC. Essential oils loaded in nanosystems: a developing strategy for a successful therapeutic approach. Evid Based Complement Alternat Med 2014; 2014:651593. doi: 10.1155/2014/651593 [Crossref] [ Google Scholar]
- Adorjan B, Buchbauer G. Biological properties of essential oils: an updated review. FlavourFragr J 2010; 25:407-26. doi: 10.1002/ffj.2024 [Crossref] [ Google Scholar]
- Negi PS, Chauhan AS, Sadia GA, Rohinishree YS, Ramteke RS. Antioxidant and antibacterial activities of various seabuckthorn (Hippophaerhamnoides L) seed extracts. Food Chem 2005; 92:119-124. doi: 10.1016/j.foodchem.2004.07.009 [Crossref] [ Google Scholar]
- Indu MN, Hatha AM, Abirosh C, Harsha U, Vivekanandan G. Antimicrobial activity of some of the south-Indian spices against serotypes of Escherichia coli, Salmonella, Listeria monocytogenes and Aeromonas hydrophila. Braz J Microbiol 2006; 37:153-8. doi: 10.1590/S1517-83822006000200011 [Crossref] [ Google Scholar]
- Sutherland J, Miles M, Hedderley D, Li J, Devoy S, Sutton K. In vitro effects of food extracts on selected probiotic and pathogenic bacteria. Int J Food Sci Nutr 2009; 60:717-727. doi: 10.3109/09637480802165650 [Crossref] [ Google Scholar]
-
Panda SK, Rath CC. Phytochemicals as natural antimicrobials: Prospects and challenges. In: Gopta VK, ed. Bioactive phytochemicals: perspectives for modern medicine. New Delhi, India: Daya Publishimng House; 2012. p. 329-89.
- Buchbauer G, Jirovetz L, Jäger W, Plank C, Dietrich H. Fragrance compounds and essential oils with sedative effects upon inhalation. Int J Pharm Sci Rev Res 1993; 82:660-4. doi: 10.1002/jps.2600820623 [Crossref] [ Google Scholar]
- Turek C, Stintzing FC. Stability of essential oils: a review. Compr Rev Food Sci F 2013; 12:40-53. doi: 10.1111/1541-4337.12006 [Crossref] [ Google Scholar]
- Yang M, Gu Y, Yang D, Tang X, Liu J. Development of triptolide-nanoemulsion gels for percutaneous administration: physicochemical, transport, pharmacokinetic and pharmacodynamic characteristics. J Nanobiotechnol 2017; 15:88. doi: 10.1186/s12951-017-0323-0 [Crossref] [ Google Scholar]
- Zainol NA, Ming TS, Darwis Y. Development and characterization of cinnamon leaf oil Nanocream for topical application. Indian J Pharm Sci 2015; 77:422. doi: 10.4103/0250-474X.164785 [Crossref] [ Google Scholar]
- Ghaderi-Ghahfarokhi M, Barzegar M, Sahari MA, Gavlighi HA, Gardini F. Chitosan-cinnamon essential oil nano-formulation: Application as a novel additive for controlled release and shelf life extension of beef patties. Int J Biol Macromol 2017; 102:19-28. doi: 10.1016/j.ijbiomac.2017.04.002 [Crossref] [ Google Scholar]
- Liu Y, Wang S, Zhang R, Lan W, Qin W. Development of poly (lactic acid)/chitosan fibers loaded with essential oil for antimicrobial applications. Nanomaterials 2017; 7:194. doi: 10.3390/nano7070194 [Crossref] [ Google Scholar]
- Cui H, Li W, Li C, Vittayapadung S, Lin L. Liposome containing cinnamon oil with antibacterial activity against methicillin-resistant Staphylococcus aureus biofilm. Biofouling 2016; 32:215-25. doi: 10.1080/08927014.2015.1134516 [Crossref] [ Google Scholar]
- Aldawsari HM, Badr-Eldin SM, Labib GS, El-Kame AH. Design and formulation of a topical hydrogel integrating lemongrass-loaded nanosponges with an enhanced antifungal effect: in vitro/in vivo evaluation. Int J Nanomedicine 2015; 10:893. doi: 10.2147/IJN.S74771 [Crossref] [ Google Scholar]
- Kumar S, Trotta F, Rao R. Encapsulation of babchi oil in cyclodextrin-based nanosponges: physicochemical characterization, photodegradation, and in vitro cytotoxicity studies. Pharmaceutics 2018; 10:169. doi: 10.3390/pharmaceutics10040169 [Crossref] [ Google Scholar]
- Cavalli R, Trotta F, Tumiatti W. Cyclodextrin-based nanosponges for drug delivery. J Incl Phenom Macrocycl Chem 2006; 56:209-13. doi: 10.1016/B978-0-12-813741-3.00005-4 [Crossref] [ Google Scholar]
- Pawar VA, Bhagat TB, Toshniwal MR, Mokashi ND, Khandelwal KR. Formulation and evaluation of dental gel containing essential oil of coriander against oral pathogens. Int Res J Pharm 2013; 4:48-54. doi: 10.7897/2230-8407.041012 [Crossref] [ Google Scholar]
- Pandey A, Jagtap JV, Polshettiwar SA. Formulation and evaluation of in vitro antimicrobial activity of gel containing essential oils and effect of polymer on their antimicrobial activity. Int J Pharm Pharm Sci 2011; 3:234-7. doi: 10.13040/IJPSR.0975-8232 [Crossref] [ Google Scholar]
- Zakaria AS, Afifi SA, Elkhodairy KA. Newly developed topical cefotaxime sodium hydrogels: Antibacterial activity and in vivo evaluation. Biomed Res Int 2016; 2016:6525163. doi: 10.1155/2016/6525163 [Crossref] [ Google Scholar]
- Swaminathan S, Pastero L, Serpe L, Trotta F, Vavia P. Cyclodextrin-based nanosponges encapsulating camptothecin: physicochemical characterization, stability and cytotoxicity. Eur J Pharm Biopharm 2010; 74:193-201. doi: 10.1016/j.ejpb.2009.11.003 [Crossref] [ Google Scholar]
- Moslemi HR, Hoseinzadeh H, Badouei MA, Kafshdouzan K, Fard RM. Antimicrobial activity of Artemisia absinthium against surgical wounds infected by Staphylococcus aureus in a rat model. Indian J Microbiol 2012; 52:601-4. doi: 10.1007/s12088-012-0283-x [Crossref] [ Google Scholar]
- Stratford AF, Zoutman DE, Davidson JS. Effect of lidocaine and epinephrine on Staphylococcus aureus in a guinea pig model of surgical wound infection. PlastReconstr Surg 2002; 110:1275-9. doi: 10.1097/01.PRS.0000025427.86301.8A [Crossref] [ Google Scholar]
-
Coyle MB. Manual of antimicrobial susceptibility testing. BCIT Imaging Services; 2005.
- Gupta M, Vyas SP. Development, characterization and in vivo assessment of effective lipidic nanoparticles for dermal delivery of fluconazole against cutaneous candidiasis. Chem Phys Lipids 2012; 165:454-61. doi: 10.1016/j.chemphyslip.2012.01.006 [Crossref] [ Google Scholar]